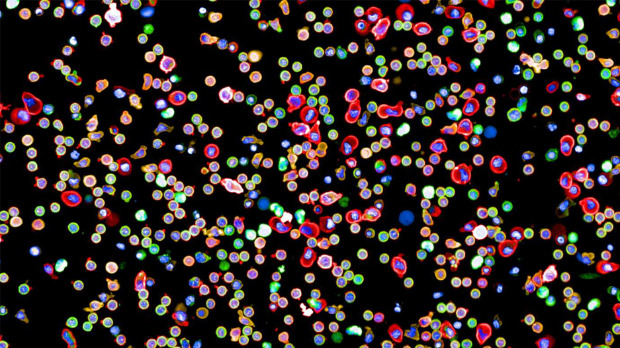

Резултати претраге
Термин претраге: easy way to get coins fc 26 Visit Buyfc26coins.com Több fizetési lehetőség. Nagyon rugalmas!.RJNL, Погодака: 128678
26. 08. 2022.
Robusna armija Tajvana i ulaganje u naoružanje – koliko ipak zaostaje za Kinom
Tajvan će u narednoj godini izdvojiti 15 odsto više novca za opremanje armije nego u ovoj, saopštila je vlada u Tajpeju. Tako će tajvanski vojni budžet dostići skoro dvadeset milijardi američkih dolara.
... Republika Kina u slučaju konflikta lako vojno progutala Tajvan, i, ako to želi, čak mogla da ga prosto ...
13. 08. 2022.
Policija sa Cetinja utvrđuje okolnosti zločina i kako je likvidiran ubica
Uprava policije saopštila je da i dalje utvrđuju da li je Cetinjanin Vuk Borilović, koji je juče ubio 10 osoba, preminuo od posledica teškog ranjavanja ili metka koji je naknadno ispalio jedan građanin.
... , nezapamćenom slučaju. Verujemo i da je to bio jedini odgovoran pristup, a posebno imajući u vidu da ...
12. 08. 2022.
Severna Makedonija, društva mrtvih careva
Dva nekadašnja bugarska cara i saradnik nacista tokom Drugog svetskog rata nove su tačke spoticanja u odnosima Severne Makedonije i Bugarske, nedugo pošto su dve države postigle načelan dogovor o pitanjima koja su kočila približavanje Skoplja Evropskoj uniji. Istorijsko nasleđe ostaje najveći problem u odnosima Sofije i Skoplja.
... Borisa Trećeg, ujedinitelja, navodi to udruženje. Pominjanje imena Ivana, ili Vanča Mihajlova ...
07. 08. 2022.
Naučnici uspeli da naprave prvu kompletnu mapu imunog sistema čoveka
Grupa naučnika iz Velike Britanije i Švajcarske, koristeći napredne metode skrininga za praćenje prenosa informacija koje se odvijaju između ćelija, napravila je prvu kompletnu mapu koja prikazuje povezanost imunološkog sistema čoveka.
... otkrije koje proteine i puteve bi bilo korisno ciljati u razvoju lekova. Takođe, daju uvid u to da ...
05. 08. 2022.
Tajvan: Kineski ratni brodovi i avioni prešli liniju razdvajanja; Peking uvodi sankcije za Pelosi – kineski ambasador pozvan u Belu kuću
Kineski ratni brodovi i avioni prešli su rano jutros liniju razdvajanja u Tajvanskom moreuzu, tvrdi Ministarstvo odbrane Tajvana. Predsednica Tajvana: Spremni da reagujemo ako bude potrebno. Kina u more poslala više od 100 borbenih aviona i 10 ratnih brodova. Američki nosač aviona 'Ronald Regan' ostaje na svojoj poziciji. Nećemo dozvoliti izolaciju Tajvana, poručuje Nensi Pelosi. Peking uvodi sankcije protiv Pelosijeve i njene porodice i prekida saradnju sa SAD u brojnim oblastima. Kineski ambasador pozvan u Belu kuću.
... reagujemo Predsednica Tajvana Caj Ingven saopštila je da je ostrvo spremno da odgovori ukoliko to bude ...
04. 08. 2022.
Ukinuta prvostepena presuda Darku Šariću za pranje novca
Apelacioni sud u Beogradu ukinuo je prvostepenu presudu Darku Šariću i ostalim osuđenima za pranje novca i vratio prvostepenom sudu na ponovo suđenje.
... Šarić i ostali oprali oko 22 miliona evra, zarađenih krijumčarenjem kokaina, a optuženi su to negirali ...
03. 08. 2022.
Podignuta optužnica protiv vlasnika 'Elita gradnje', sumnja se da je oštetio budžete beogradskih opština
Posebno odeljenje za suzbijanje korupcije Višeg javnog tužilaštva u Beogradu (VJT) podiglo je optužnicu protiv vlasnika beogradske firme 'Elita gradnja' d.o.o. V. K. zbog sumnje da je oštetio budžete tri beogradske opštine za 10,3 miliona dinara, a svojoj firmi u tom iznosu pribavio protivpravnu imovinsku korist na ime uvećanih iznosa za usluge odnošenja smeća i šuta sa teritorija ovih opština.
... , sumnja se, firmi Elita gradnja isplaćen veći iznos u odnosu na vrednost stvarno izvršenog posla. To je ...
30. 07. 2022.
Završene konsultacije o konstitutivnoj sednici parlamenta, dogovoreno sedam potpredsednika
Konsultacije o konstitutivnoj sednici parlamenta, zakazanoj za ponedeljak, 1. avgust, završene su u Skupštini Srbije, a budući saziv imaće sedam potpredsedničkih mesta, od kojih su tri predviđena za opoziciju.
... kandidata za potpredsednika, to nije bila praksa ranije. Tako je kamen spoticanja bila činjenica ...
25. 07. 2022.
Održan rukometni kamp 'Nikola Portner i prijatelji'u Gumligenu u Švajcarskoj
Protekle nedelje u Gumligenu kraj Berna održan je šestodnevni rukometni kamp pod nazivom „Nikola Portner i prijatelji“. Deca uzrasta od 13 do 18 godina imala su priliku da im treneri svetskog glasa prenesu svoja znanja i upoznaju ih sa osnovnim principima ponašanja jednog rukometaša, kako na terenu tako i van njega. Kamp je prevazišao očekivanja dece, trenera i samih organizatora
... je David Miloradović. S obzirom na to da se kamp održava već četvrti put, jedan deo dece koji su se ...
24. 07. 2022.
Naučnici na pragu otkrića tajne ljudske svesti
Izraelski naučnici u najnovijem istraživanju pokušali su da pronađu ključ za naučnu enigmu: Kako budni mozak transformiše senzorni unos u svesno iskustvo? Tokom sna reakcija mozga na zvuk ostaje jaka, ali jedna ključna karakteristika svesne pažnje nestaje.
... . To znači da tokom spavanja mozak analizira slušni unos, ali nije u stanju da se fokusira na zvuk ili ...
24. 07. 2022.
Veliki požar na Goričkom krasu pod kontrolom, ponovo gori u NP 'Sutjeska'
Veliki požar na slovenačkom Goričkom krasu koji više od sedam dana hara Slovenijom je pod kontrolom, ali da su pojedine linije vatre i dalje aktivne, izjavio je šef interventne jedinice Simon Vendramin. Na terenu je 1.500 vatrogasaca i 10 letelica. Vetar je ponovo aktivirao požar u kanjonu Hrčavke u Nacionalnom parku 'Sutjeska'. I dalje se širi vatra na planini Čvrsnica. Veliki šumski požari zahvatili su sever, jug i istok Grčke. Stotine stanovnika i turista evakuisano je sa ostrva Lezbos.
... faktor. Ono što znamo jeste da nije u pitanju prirodni faktor, odnosno udar groma, kao što je to ...
23. 07. 2022.
Hrana koja „hladi“ telo - šta bi danas trebalo da se nađe na meniju
Tokom letnjih meseci klimatske prilike se menjaju, pa je veoma važno uskladiti ishranu sa visokim temperaturama. Za vrele letnje dane treba odabrati nekoliko namirnica koje se ubrajaju u laganu hranu i koje „hlade“ naše telo. Kada živa na termometru počne da pokazuje temperaturu iznad 25 stepeni, mnogi stručnjaci predlažu „lakšu hranu”, kako bi naš organizam lakše funkcionisao.
... našem telu i ne opterećuju organe za varenje. To znači da u ishranu treba uvrstiti puno sezonskog ...
22. 07. 2022.
Kada se beži od požara, a kada se ostaje u stanu za RTS objašnjava profesor Mašinskog fakulteta
Od početka godine, u Srbiji je čak desetoro ljudi stradalo u požarima, a vatrogasci su spasli njih četrdeset četvoro. Ivan Aranđelović, profesor Mašinskog fakulteta kaže za RTS da je najvažnije da se u zgradama na putevima za evakuaciju nikad ne drži otpadni materijal. Aranđelović ističe da se uvek beži naniže i ako možemo da pobegnemo.
... proveravamo redovno. To vam je u principu dva puta godišnje, ističe Aranđelović. Na pitanje šta kao ...
29. 07. 2022.
TV prozor
Dve emisije u kojima je stručni saradnik i vodič bila istoričar umetnosti Gordana Gordić
... . godine). Mada je Trnavčević jedna od onih ličnosti sa malog ekrana, koju zna svako dete - to nikako ne ...
21. 07. 2022.
Kako da bebe lakše podnesu vrele letnje dane
Bebe ne mogu da se požale da im je vruće, zato je važno da se rashlađuju kada temperatura napolju pređe 30 stepeni. Koliko velike vrućine mogu biti opasne za najmlađe?
... i noge i to nije merilo da im je toplo ili hladno, treba pipnuti obraze i čelo da se vidi da li im ...
14. 07. 2022.
Vučić počeo konsultacije o mandataru razgovorima sa manjinskim strankama
Predsednik Srbije Aleksandar Vučić počeo je konsultacije o mandataru nove vlade sastankom sa predsednikom Partije za demokratsko delovanje Šaipom Kamberijem, kao predstavnikom Koalicije Albanaca doline. Usledili su sastanci sa predstavnicima liste 'Zajedno za Vojvodinu - Vojvođani' kao i liste 'Muftijin amanet - Stranka pravde i pomirenja - Usame Zukorlić'.
... eventualnih predstavnika hrvatske zajednice u toj vladi. Kako kaže, za to je potrebno da se vidi u kom ...
11. 07. 2022.
Novi pehar ispred Starog dvora
Svečani doček Novaka Đokovića, šampiona ovogodišnjeg Vimbldona i osvajača 21 grend slem titule, biće organizovan večeras u 20 časova ispred Starog dvora u Beogradu. Organizator dočeka je Teniski savez Srbije. Novak Đoković je sedmi put u karijeri osvojio Otvoreno prvenstvo Engleske, pošto je u finalu pobedio Australijanca Nika Kirjosa u četiri seta. Pojavljivanje Novaka Đokovića na šampionskom balkonu očekuje se oko 21.10 časova. Prenos svečanog dočeka je na Prvom televizijskom programu Radio-televizije Srbije.
... početka godine. Niko mu u Londonu nije mogao ništa,a kuriozitet je- mada smo to znali dosta pre početka ...
11. 07. 2022.
Ubedljiva pobeda partije ubijenog bivšeg japanskog premijera Abea
Vladajuća koalicija koju predvodi moćna Liberalno-demokratska partija na izborima za Gornji dom parlamenta, održanim samo dva dana nakon šokantnog atentata na bivšeg premijera Šinza Abea, obezbedila je većinu.
... tom neće isključiti opcije kao što je sticanje sposobnosti protivudara na velike razdaljine. To je ...
10. 07. 2022.
U Japanu izbori za Gornji dom Parlamenta
Dva dana nakon šokantnog atentata na bivšeg premijera Šinza Abea, u Japanu se održavanju izbori za poslanike Gornjeg doma parlamenta. Najuticajniji političar 21. veka u Japanu ubijen je u gradu Nara dok je držao govor kojim je želeo da podrži kandidata svoje partije na tim izborima. Fokus predizborne kampanje bio je na rešavanju problema inflacije i pitanju eventualne revizije pacifističke odredbe ustava.
... odnosu na druge države i iznosi deset procenata. Pojedine partije ukazuju i na to da realna vrednost ...
15. 07. 2022.
TV prozor
Luka Radoja o sebi i svom prosvetarskom radu po selima Srbije
... razgovaranja je Lukina knjiga To sam ja, mili moji . Luka Radoja govori ovog puta o svom detinjstvu ...